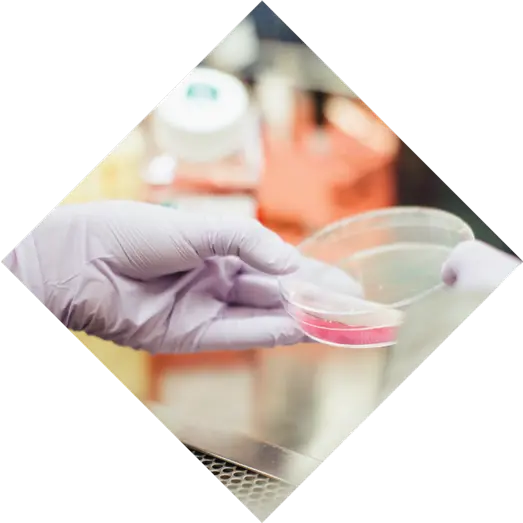
Image

Introducing Our Research-Based Foundation
The Autism Discovery and Treatment Foundation (ADTF) is a 501c3 organization dedicated to improving the lives of individuals and families living with complex medical conditions, including autism and other neurodevelopmental disorders.
Our Leucovorin Research was Recently Featured on CBS Evening News
One of our cofounders, Dr. Richard E. Frye, was recently interviewed by CBS’s Dr. Celine Gounder about our research and success in treating children with Autism using leucovorin, an old repurposed drug. To make a tax-deductible donation to our research, visit our donation page where this project and many of our foundation's other ongoing areas of research are featured.

New Book Coming Soon!
Featuring New Research from The Autism Discovery and Treatment Foundation
Dr. Frye, co-founder of ADTF, is publishing a comprehensive book on Cerebral Folate Deficiency. Designed as a practical guide for both patients and clinicians, the book includes compelling patient stories and summaries of the latest research.
Sign up now to be notified when it becomes available for purchase!

Spotlight on Research

Spotlight on Research
Other New Research

Background
It's time to understand autism.
Autism is a complex behaviorally defined neurodevelopmental disorder that affects one out of every 52 children born in the United States. There are no known causes for autism; therefore, no known measures that can be taken to prevent spectrum disorders. Autism knows no racial, ethnic, or social boundaries and can affect any family and any child.
We believe that many opportunities and answers lay ahead. Autism Discovery & Treatment Foundation is now ready to conquer new endeavors that will have lasting impact on the lives of children with autism and their families.
Our Goal
It's time to move the ball forward.
Researchers have already discovered several abnormalities in cellular metabolism that are more frequent in children with autism than in their typical peers.
Tests have been developed to look at these differences, which are referred to as biomarkers. We know there are many more biomarkers waiting to be discovered.Once a biomarker is discovered, we can work to develop treatments or interventions that “normalize” the functioning of the cell or the metabolism and ensure that the treatment works in individual children by repeatedly measuring these biomarkers.
We have observed improvements in some children who received specific treatments based on the type of abnormality or biomarker that they had. Our goal is to further study these biomarkers and potential treatments and improve the standard medical practices around Autism.

Moving treatments from laboratories to lives
Our Approach
Going Big by Going Small: A Biochemical Approach.
We aim to improve the accuracy of diagnosis and the effectiveness of treatment by identifying treatable biologically valid mechanism and causes of disease, then developing and validating practical and safe treatments.
We are searching for predictive biomarkers of autism that may facilitate early diagnosis and provide a treatment target to arrest and possibly prevent the development of autism in susceptible children.
Another component of our mission is to educate the scientists, medical professionals and general public regarding new developments in biological mechanisms and treatments.
We are searching for predictive biomarkers of autism that may facilitate early diagnosis and provide a treatment target to arrest and possibly prevent the development of autism in susceptible children.
How We Work
Putting the Pieces Together.
We are ready to advance our collective understanding of Autism by investing in research for Biomarkers and Treatments. We want to build a process that moves promising ideas from basic research to clinical products that improve lives.
Diagnostics
Fund projects that develop diagnostics and preclinical assays.
Research
Fund basic and translational research that identifies biomarkers.
Clinical Practice
Developing evidence-based guidelines for clinical practice.
Treatments
Offer safe and effective treatments for neurodevelopmental disorders.
Ask Us About: Mitochondrial DysfunctionCerebral Folate DeficiencyEpilepsy/SeizuresAutism DiagnosesBiomarkersNovel Treatments...and more!
We will be featuring questions from our followers in upcoming videos posted to social media. Submit something you are curious about and our research team may answer your question in an upcoming video! Be sure for follow us on facebook so that you will be alerted when we post a video! Follow Us on Facebook
Research that Changes Lives
Below are links to some of our publications. Click to read full studies.
Funding Meaningful Projects
Our Foundation Projections
Funding translational research projects that lead to new treatments and clinical practices for autism.
Support Our EffortsYear 1
$400K in Donations
Identify 3 new potential treatments.
Year 1
Year 2
$1M in Donations
Fund 4 Internal Projects and Begin Investigation of 1 Novel Treatment Option.
Year 3
$6M in Donations
Fund 4 Internal Projects, Move 1 Potential Treatment to Investigation, and 1 Treatment to Clinical Practice.
Year 3
Year 4
$8M in Donations
Fund 5 Internal Projects, Move 2 Potential Treatment to Investigation, and 2 Treatments to Clinical Practice.
Year 5
$10M in Donations
Fund 6 Internal Projects, Move 3 Potential Treatment to Investigation, and 3 Treatments to Clinical Practice. Develop Educational Resources for Practionners.
Year 5
Current Projects
Mitochondrial Dysfunction in Epilepsy and Autism
About this Project
Individuals with Autism Spectrum Disorder (ASD) are at an increased risk for epilepsy with the risk of new onset seizures increasing into adolescents and young adulthood. Epilepsy in individuals with ASD is more difficult to treat and is the leading cause of death in young adults with ASD. At this time we need better biomarkers of the risk for developing epilepsy in those with ASD so we can predict those that require treatment or monitoring and a better understanding of the biological mechanism that underlie epilepsy so we can develop novel effective therapies.
Mitochondrial dysfunction has been linked to epilepsy but, at this time, biomarker of mitochondrial dysfunction in the brain are very limited to research based approaches. Our laboratory has developed the ability to measure mitochondrial function in fresh human brain surgically excited to remove areas that cause epilepsy.
We have correlated mitochondrial dysfunction in these resected areas of brain with high frequency oscillations (HFOs) from electrophysiological recordings obtained preoperatively during the epilepsy evaluation. This research will focus on studying mitochondrial dysfunction as a cause of epilepsy in individuals with and without ASD as well as the correlation with these areas of mitochondrial dysfunction with HFOs that can be recorded non-invasively as a biomarker of mitochondrial associated epilepsy.
Such research will improve the identification of epilepsy in individuals with ASD as well as identification of mitochondrial dysfunction in the brain so effective targeted treatments can be provided to control seizures.
Help Fund This ProjectBioenergetic Signatures of Neurodevelopmental Regression
Transgenerational Folate Abnormalities
The COMPREHENSIVE Assessment of Autism Health
Metabolic Treatments to Improve the Lives of Children with ASD
Leucovorin Treatment






